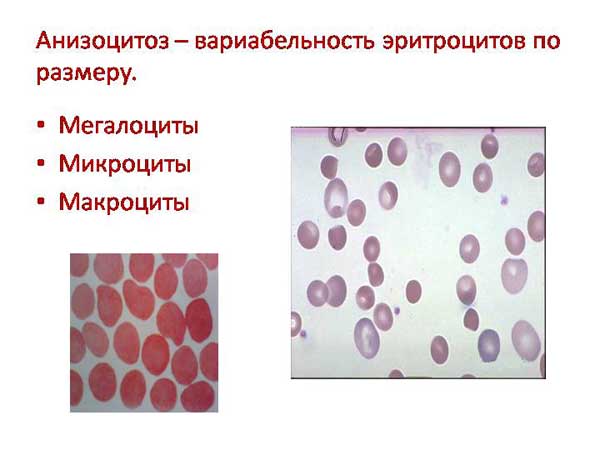

Что это такое MCV
Это средний объем красных кровяных клеток. Форма и размеры этих клеток являются ключевыми характеристиками. Их оценка проводится в ходе клинического общего анализа крови. Измеряются эти параметры в фемтолитрах (фл) и микрометрах в кубе (мкм³).
Индекс MCV предоставляет возможность получить подробные сведения о характеристиках, включая диаметр эритроцитов.
Этот показатель вычисляется путем деления объема эритроцитов, находящихся в одном кубическом миллиметре крови, на количество клеток.
Учитываются только однородные клетки. Если в процессе расчета присутствует множество клеток с различными размерами и формами, то значение MCV будет некорректным.
MCV, или средний объем эритроцитов, является важным показателем в анализе крови, который помогает врачам оценить состояние пациента. Этот параметр отражает средний размер красных кровяных клеток и может указывать на различные заболевания. Врачи отмечают, что низкий уровень MCV может свидетельствовать о железодефицитной анемии, когда организм не получает достаточного количества железа для производства эритроцитов. В то же время высокий уровень MCV может указывать на мегалобластную анемию, связанную с дефицитом витамина B12 или фолиевой кислоты. Таким образом, анализ MCV является важным инструментом для диагностики и мониторинга различных заболеваний, позволяя врачам принимать более обоснованные решения о лечении и профилактике. Правильная интерпретация этого показателя в контексте других анализов и клинической картины пациента помогает врачам обеспечить более точную диагностику и эффективное лечение.

Какие существуют нормы
Индекс MCV – это показатель, который изменяется с возрастом и отличается для мужчин и женщин. Наивысшие значения наблюдаются у новорожденных, где они варьируются от 90 до 140 фл.
К концу первого года жизни ребенка этот индекс составляет от 71 до 84 фл. В возрасте от 5 до 10 лет MCV у детей колеблется в диапазоне 75-87 фл.
В подростковом возрасте (15-18 лет) нормы для девушек увеличиваются и составляют 78-98 мкм3. В период с 18 до 45 лет средний объем красных кровяных клеток у женщин достигает 81-100 мкм3.
Для юношей в возрасте от 15 до 18 лет нормальные значения находятся в пределах 79-95 мкм3, а начиная с 18 лет – 80-99 мкм3.
У взрослых людей в возрасте от 45 до 65 лет, независимо от пола, индекс MCV составляет 81-101 мкм3.
| Показатель | Значение (фемтолитры, фл) | Интерпретация |
|---|---|---|
| MCV (Средний объем эритроцитов) | 80-100 | Нормальный объем эритроцитов |
| MCV < 80 | Микроцитоз | Эритроциты меньше нормы, может указывать на железодефицитную анемию, талассемию, анемию хронических заболеваний |
| MCV > 100 | Макроцитоз | Эритроциты больше нормы, может указывать на дефицит витамина B12 или фолиевой кислоты, заболевания печени, алкоголизм |
Зачем нужно знать эти цифры?
Если результаты анализа показывают значение, соответствующее норме, такой результат называется нормоцитарным.
Когда индекс оказывается ниже 80 мкм³, то есть показатель MCV снижен, это указывает на наличие микроцитоза у пациента.
Если же уровень превышает 100, то речь идет о макроцитозе.
Возраст обычно оказывает влияние на этот показатель. Он может варьироваться, как в меньшую, так и в большую сторону, различаясь между девушками и юношами, а у пожилых людей значения выравниваются. У здоровых пожилых людей показатели одинаковы, независимо от пола.
Изменение нормального объема эритроцитов может свидетельствовать о наличии определенной патологии.
Показатель MCV (средний объем эритроцитов) в анализе крови вызывает много вопросов у людей, интересующихся своим здоровьем. Многие считают, что это важный маркер, который помогает понять состояние крови и выявить возможные заболевания. Например, низкий уровень MCV может указывать на железодефицитную анемию, тогда как высокий — на мегалобластную анемию или другие нарушения. Люди отмечают, что результаты анализа часто требуют дополнительной интерпретации, и важно консультироваться с врачом для получения точной информации. Некоторые также делятся опытом, когда изменение уровня MCV помогло выявить скрытые проблемы со здоровьем. В целом, этот показатель воспринимается как важный элемент общего анализа крови, который может дать ценную информацию о состоянии организма.

Показания к проведению исследования
Одной из причин, по которым проводится анализ на уровень эритроцитов, является подозрение на наличие заболевания. Например, врач может заподозрить у пациента макроцитарную анемию или другие отклонения в функциональных характеристиках эритроцитов.
Такое исследование необходимо для мониторинга эффективности лечения, и оно касается всех участников диспансеризации, а также тех, кто готовится к хирургическому вмешательству.
Анализ следует провести в следующих случаях:
- гормональные нарушения;
- сбои в обмене веществ;
- избыточная масса тела;
- сахарный диабет;
- ослабленный иммунитет.
Подготовка к анализу
Перед тем как отправиться на исследование, важно тщательно подготовиться к сдаче анализов. Специалисты советуют за день до визита в лабораторию:
- избегать радио- и рентгеновского облучения;
- не проводить физиотерапевтические процедуры;
- ограничить физические и умственные нагрузки;
- не делать инъекции внутривенно и внутримышечно;
Кровь следует сдавать утром натощак, в хорошем настроении, без стресса и после полноценного сна.
Несоблюдение этих простых рекомендаций может привести к искажению результатов, что, в свою очередь, может стать причиной неверного диагноза.
Если врач назначает повторный забор материала, необходимо воздержаться от пищи как минимум за 240 минут. Лучше всего проводить процедуру в то же время, в аналогичных условиях и в одной и той же медицинской организации.

Выполнение забора биоматериала
Капиллярная кровь для общего анализа раньше бралась из среднего пальца. Однако, с учетом того, что результаты анализов, полученных из венозной крови, более точны и информативны, этот метод постепенно утрачивает свою популярность.
- Сначала медсестра накладывает резиновый жгут выше локтя пациента, прежде чем ввести иглу в вену. Для того чтобы вена стала более заметной и наполнилась кровью, пациенту предлагается несколько раз сжимать и разжимать кулак. Участок, где будет произведен прокол, тщательно обрабатывается спиртом.
- Затем в вену вводится стерильная игла. Темно-красная кровь начинает поступать по игле и заполняет чистую пробирку или одноразовый шприц. Для полноценного анализа необходимо собрать не менее 5 мл крови.
- Как только нужный объем собран, жгут ослабляется, к месту укола прикладывается спиртовой тампон, и игла аккуратно извлекается.
Чтобы предотвратить образование синяка под кожей, тампон следует прижимать к руке не менее 5 минут. Если у пациента наблюдается плохая свертываемость крови, это время увеличивается до 7-10 минут, пока не образуется тромбик. Важно выдержать необходимое время, чтобы избежать появления большого синяка в месте забора биоматериала.
Если лаборант обладает достаточным опытом, все процедуры занимают всего несколько минут и вызывают минимальные болезненные ощущения. На этом работа медсестры завершается, и ответственность переходит к лаборантам и врачам.
Лабораторное исследование
Свежий биоматериал помещается в анализатор, который автоматически определяет все виды клеток и общее количество эритроцитов в образце.
Если прибор фиксирует значительные отклонения от норм и обнаруживает большое количество аномальных клеток, материал подвергается повторной проверке. Лаборант дополнительно изучает образец под микроскопом, чтобы уточнить и расширить полученные данные.
Не все современные клинические лаборатории оборудованы автоматическими анализаторами. В некоторых случаях подсчет клеток осуществляется традиционным методом — визуально, с помощью микроскопа. Время, необходимое для анализа, может варьироваться в зависимости от загруженности сотрудников и используемого метода.
Полученные результаты лаборанты фиксируют на бланке, и в течение 1-7 дней пациент получает их на руки. Интерпретация и уточнение диагноза остаются в компетенции врачей.
В таблице общего анализа представлены различные показатели. Здесь указано количество эритроцитов, их характеристики, а также данные о ретикулоцитах — незрелых клетках. Указывается уровень гемоглобина в одном эритроците. Рядом с каждым значением приводятся нормальные показатели для удобства сравнения.
Расшифровка результата
При нормальном уровне эритроцитов можно говорить о наличии нормоцитарной анемии, которая может быть следующих типов:
- гемолитическая;
- апластическая;
- геморрагическая;
- печеночная;
- эндокринная.
Высокий показатель
Когда в организме наблюдается повышенное количество красных кровяных телец, это может указывать на развитие макроцитарной анемии у пациента.
Причины возникновения данной проблемы могут быть разнообразными:
- дефицит микроэлементов (например, витамина В12);
- недостаток фолиевой кислоты;
- мегалобластная анемия;
- наличие опухолевых образований;
- гипотиреоз;
- нарушения всасывания в кишечнике;
- заболевания печени;
- микседема;
- патологии поджелудочной железы;
- заболевания костного мозга с высоким уровнем лейкоцитов;
- токсичное воздействие медикаментов;
- алкогольная интоксикация.
Отмечается, что объем эритроцитов может быть немного увеличен у курильщиков и людей, проходящих гормональную терапию.
У пациентов с хроническим алкоголизмом также фиксируется макроцитоз, при этом уровень гемоглобина остается в пределах нормы. Этот аспект может помочь в ранней диагностике алкоголизма. Однако после 100 дней воздержания от алкоголя индекс MCV возвращается к норме.
Частые кровотечения также могут способствовать повышению этого индекса.
В некоторых случаях макроцитоз может развиваться после длительного приема антидепрессантов, хотя четкая связь между этими факторами пока не установлена.
Первоначальными признаками повышенного уровня эритроцитов являются румянец на лице, покраснение кожи, головные боли и головокружение.
Низкие значения
Снижение показателя MCV указывает на наличие микроцитарной анемии, которая может возникать по следующим причинам:
- хронические заболевания и инфекции;
- дефицит железа;
- развитие злокачественных новообразований;
- отравление свинцом;
- низкий уровень гемоглобина;
- наследственные формы анемии;
- прием некоторых медикаментов.
Одной из причин пониженного индекса является нарушение водно-электролитного баланса, известное как гипертоническая дегидратация. При этом состоянии уменьшается объем жидкости в клетках из-за недостатка воды в тканях, что приводит к обезвоживанию, вызванному недостаточным поступлением влаги и нехваткой гипотонической жидкости в организме.
Показатель MCV ниже нормы наблюдается при гипохромных анемиях, микроцитозе или снижении синтеза гемоглобина. Гемоглобин напрямую влияет на форму и насыщенность эритроцитов.
Когда уровень гемоглобина оказывается ниже необходимого, объем красных кровяных телец также уменьшается. Снижение его синтеза может происходить и при генетических заболеваниях крови, таких как талассемия.
Если у человека возникают симптомы, такие как слабость, быстрая утомляемость, шум в ушах, рассеянность, выраженная бледность кожи и ухудшение памяти, ему следует обратиться к врачу. Возможно, произошло снижение количества эритроцитов или их объема.
Изменчивость клеток
У человека могут быть выявлены не только отклонения в показателе MCV, но и анизоцитоз в некоторых случаях.
При данной патологии под микроскопом наблюдается большое количество клеток, отличающихся по размеру, что приводит к повышенной вязкости крови. Параметр MCV имеет тесную связь с другим показателем, RDW, который отражает изменчивость клеток по их величине.
Тщательное исследование крови имеет огромное значение. Ошибочная диагностика может привести к серьезным последствиям. В случае сомнений лучше повторить анализ, чем подвергать себя неправильному лечению.
Вопрос-ответ
Когда следует беспокоиться о высоком уровне MCV?
Макроцитарный (высокий MCV). Если MCV превышает 100 фл, это свидетельствует о макроцитарной анемии, которая часто связана с: дефицитом витамина B12, дефицитом фолата, болезнью печени.
Как повысить уровень MCV в анализе крови?
Для повышения уровня MCV (средний объем эритроцитов) в анализе крови важно обратить внимание на питание и образ жизни. Увеличьте потребление продуктов, богатых витаминами B12 и фолиевой кислотой, таких как мясо, рыба, яйца, зеленые листовые овощи и бобовые. Также стоит следить за уровнем железа в организме, так как его недостаток может влиять на размеры эритроцитов. В случае подозрения на анемию или другие заболевания, обязательно проконсультируйтесь с врачом для получения рекомендаций и возможного лечения.
Советы
СОВЕТ №1
Обратите внимание на нормальные значения MCV. Понимание диапазона нормальных показателей (80-100 фемтолитров) поможет вам лучше интерпретировать результаты анализа и выявить возможные отклонения.
СОВЕТ №2
Не игнорируйте другие показатели анализа крови. MCV следует рассматривать в контексте других параметров, таких как уровень гемоглобина и количество эритроцитов, чтобы получить полное представление о состоянии вашего здоровья.
СОВЕТ №3
Консультируйтесь с врачом при отклонениях. Если ваш MCV выходит за пределы нормы, обязательно обсудите это с врачом, который сможет назначить дополнительные исследования и определить возможные причины изменений.
СОВЕТ №4
Следите за своим питанием. Низкий уровень MCV может быть связан с дефицитом железа или витаминов. Убедитесь, что ваш рацион сбалансирован и включает необходимые микроэлементы для поддержания нормального уровня красных кровяных клеток.